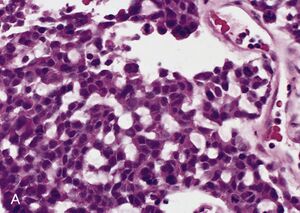

سرطان القشرة الكظرية
| سرطان القشرة الكظرية | |
|---|---|
| الأسماء الأخرى | سرطان قشرة الغدة الكظرية ، سرطان قشر الكظر '،' 'سرطانة قشرة الغدة الكظرية' ، سرطان قشرة الغدة الكظرية |
| صورة مجهرية لسرطان قشر الكظر (يسار الصورة - أزرق غامق) والقشرة الكظرية التي نشأت منها (أعلى يمين الصورة - وردي / أزرق فاتح). يوجد لب الغدة الكظرية الحميد (منتصف يمين الصورة - رمادي / أزرق). صبغة هيماتوكسيلين ويوزين. | |
| التخصص | علم الأورام |
سرطان القشرة الكظرية (Adrenocortical Carcinoma) (ACC), هو سرطان عدواني ينشأ في قشرة الغدة الكظرية (الأنسجة المنتجة لهرمون السترويد ).
Aسرطان القشرة الكظرية ملفت للعديد من المتلازمات الهرمونية التي يمكن أن تحدث في المرضى الذين يعانون من أورام ("وظيفية") المنتجة لهرمون الستيرويد، بما في ذلك متلازمة كوشينگ، متلازمة كون، ترجيل، و تأنيث. غالبًا ما غزا سرطان القشرة الكظرية الأنسجة القريبة أو انتقل إلى أعضاء بعيدة في وقت التشخيص، ومعدل البقاء على قيد الحياة لمدة 5 سنوات بشكل عام حوالي 50٪.[1]
يعتبر سرطان القشرة الكظرية ورمًا نادرًا، ويحدث من واحد إلى اثنين لكل مليون نسمة سنويًا..[2][3]له توزيع ثنائي حسب العمر، مع تجمعات الحالات في الأطفال دون سن الخامسة والبالغين من 30 إلى 40 عامًا.[2] تم عزل خط الخلية H295R المنتج للستيويد المستجيب للأنجيوتنسين II على نطاق واسع في الأصل من ورم تم تشخيصه على أنه سرطان القشرة الكظرية.[4][5]
العلامات والأعراض
قد يظهر سرطان القشرة الكظرية بشكل مختلف عند الأطفال والبالغين. معظم الأورام عند الأطفال تكون وظيفية، ويعد التذكير إلى حد بعيد أكثر أعراض العرض شيوعًا، تليها متلازمة كوشينگ والبلوغ المبكر.[2] Aبين البالغين الذين يعانون من متلازمات هرمونية، متلازمة كوشينگ وحدها هي الأكثر شيوعًا، تليها كوشينگ المختلطة والتذكير (الإفراط في إنتاج الهرمون القشري السكري والأندروجين). التأنيث و متلازمة كون ( الهرمونات القشرية المعدنية الزائدة) تحدث في أقل من 10٪ من الحالات. نادرًا ما تم الإبلاغ عن فرط إفراز الكاتيكولامينات الشبيه بورم القواتم في سرطانات القشرة الكظرية.[6] الأورام غير الوظيفية (حوالي 40٪ ) عادة ما تظهر بألم في البطن أو الخاصرة، دوالي الخصية، وخثرة في الوريد الكلوي[7] أو قد تكون بدون أعراض ويتم اكتشافها بالمصادفة.[3]
يجب تقييم جميع المرضى الذين يعانون من سرطان القشرة الكظريةالمشتبه به بعناية بحثًا عن علامات وأعراض المتلازمات الهرمونية. بالنسبة لمتلازمة كوشينگ (زيادة الهرمون القشراني السكري)، تشمل زيادة الوزن، وهزال العضلات، والخطوط الأرجوانية على البطن، و " حدبة الجاموس " الدهنية على الرقبة، والوجه "الشبيه بالقمر"، والجلد الرقيق والرخو. يكون التذكير (زيادة الأندروجين) أكثر وضوحًا عند النساء، وقد تؤدي إلى زيادة شعر الوجه والجسم، وحب الشباب، وتضخم البظر، وتغليظ الصوت، وخشونة ملامح الوجه، وإنقطاع الطمث. تتميز متلازمة كون ( الهرمونات القشرانية المعدنية الزائدة) بفرط ضغط الدم، والذي يمكن أن يؤدي إلى الصداع ونقص پوتاسيوم الدم (انخفاض الپوتاسيوم في الدم، والذي يمكن أن يؤدي بدوره إلى ضعف العضلات والارتباك والخفقان)، وانخفاض نشاط الرينين في البلازما، وارتفاع مستوى الألدوستيرون في الدم. يُلاحظ التأنيث ( زيادة هرمون الاستروجن ) بسهولة عند الرجال، ويتضمن تضخم الثدي، وانخفاض الرغبة الجنسية، والعجز الجنسي.[2][3][8]
الفيزيولوجيا المرضية
العامل المسبب الرئيسي لسرطان القشرة الكظرية غير معروف، على الرغم من أن العائلات المصابة بمتلازمة لي-فراوميني، الناتجة عن طفرة تعطيل وراثية في TP53، قد زادت من مخاطرها. وقد تبين أن العديد من الجينات إلى أن تحور متكرر، بما في ذلك TP53، CTNNB1، MEN1، PRKAR1A، RPL22، و DAXX.[9][10] غالبًا ما يتم تضخيم جين التيلوميراز TERT بينما يتم غالبًا حذف ZNRF3 و CDKN2A بشكل متماثل.[10] تعتبر الجينات h19 وعامل النمو الشبيه بالأنسولين IGF-II ) و p57 kip2 مهمة لنمو الجنين وتطوره. تقع على الكروموسوم 11 ع. ينخفض التعبير عن الجين h19 بشكل ملحوظ في كل من السرطانات القشرية الكظرية التي لا تؤدي وظيفتها وتلك العاملة، خاصة في الأورام التي تنتج الكورتيزول والألدوستيرون. أيضًا، يحدث فقدان في نشاط منتج الجين p57 kip2 في الأورام الغدية المسببة للتذكير وسرطان الغدة الكظرية. في المقابل، فقد ثبت أن التعبير الجيني عامل النمو الشبيه بالأنسولين II مرتفع في سرطان الغدة الكظرية. أخيرًا، يكون التعبير الجيني c-myc مرتفعًا نسبيًا في الأورام، وغالبًا ما يرتبط بسوء التشخيص..[11]
أورام قشر الكظر الثنائية أقل شيوعًا من الأورام أحادية الجانب. يمكن تمييز غالبية الأورام الثنائية وفقًا لحجم العقيدات وجانبها: داء قشر الكظر المصطبغ العقيدي البدائي، والذي يمكن أن يكون فردياً أو جزءًا من مجمع كارني، وتضخم الغدة الكظرية الكلي الثنائي الأولي.[citation needed]
تنتشر النقيلات بشكل شائع في الكبد والرئة.[12]
التشخيص
النتائج المخبرية
يجب تأكيد المتلازمات الهرمونية بالفحوصات المخبرية. تشمل النتائج المعملية لمتلازمة كوشينگ زيادة گلوكوز الدم (سكر الدم) وزيادة الكورتيزول في البول. يتم تأكيد التذكير الكظري من خلال اكتشاف وجود فائض من مصل أندروستينيديون و ديهيدرو إيبي أندروستيرون. تشمل النتائج في متلازمة كون نقص پوتاسيوم الدم، وانخفاض نشاط الرينين في البلازما، وارتفاع مستوى الألدوستيرون في الدم. تم تأكيد التأنيث مع اكتشاف وجود فائض من هرمون الاستروجين في الدم.[citation needed]
التصوير
تعتبر الدراسات الإشعاعية للبطن، مثل الأشعة المقطعية والتصوير بالرنين المغناطيسي، مفيدة في تحديد موقع الورم، وتمييزه عن الأمراض الأخرى، مثل سرطان القشرة الكظرية، وتحديد مدى غزو الورم للأعضاء والأنسجة المحيطة. في التصوير المقطعي المحوسب، يظهر مظهرًا غير متجانس بسبب النخر والتكلسات والنزيف. بعد حقن التباين، يظهر تحسناً محيطياً. ومن الشائع أيضًا غزو الهياكل المجاورة مثل الكلى والوريد الأجوف والكبد والعقد الليمفاوية خلف الصفاق.[13]
في التصوير بالرنين المغناطيسي، يُظهر كثافة منخفضة على الصور الموزونة T1، وإشارة T2 عالية مع تعزيز قوي للتباين غير المتجانس وتبييض بطيء. قد تظهر المناطق النزفية إشارة T1 عالية.[13]
علم الأمراض
غالبًا لا يتم أخذ خزعة من أورام الغدة الكظرية قبل الجراحة، لذلك يتم تأكيد التشخيص عند فحص العينة الجراحية من قبل أخصائي علم الأمراض. بشكل عام، غالبًا ما تكون سرطانات القشرة الكظرية كبيرة، مع سطح قطع أصفر أسمر، ومناطق نزيف و نخر. في الفحص المجهري، يظهر الورم عادة صفائح من الخلايا غير النمطية مع بعض التشابه مع خلايا قشرة الغدة الكظرية الطبيعية. يساعد وجود الغزو والنشاط الانقسامي الفتيلي في التفريق بين السرطانات الصغيرة و اورام القشرة الكظرية الغدية
.[6] تتضمن العديد من المتغيرات النادرة نسبيًا لسرطان القشرة الكظرية ما يلي::
- سرطان الخلايا الكظرية القشري المتعلق بالخلايا المنتبجة
- سرطان الغدة الكظرية المخاطي
- ساركوما سرطانية
- سرطان قشر الكظر الغدي الحرشفي
- سرطان الخلايا الكظرية ذو الخلايا الصافية
التشخيص التفريقي

يشمل التشخيص التفريقي: [citation needed]
يتم تمييز سرطانات القشرة الكظرية بشكل أكثر شيوعًا عن أوارم القشرة الكظرية الغدي (نظائرها الحميدة) بواسطة نظام فايس،[15] علي النحو التالي:[16]
| الخصائص[16] | نتيجة |
|---|---|
| درجة نووية عالية (مكبرة، بيضاوية إلى مفصصة، ذات حبيبات خشنة إلى كروماتين مفرط اللون ويمكن تمييزها بسهولة، نوى بارزة))[17] | 1 |
| انقسام فتيلي أكثر من 5/50 حقول طاقة عالية | 1 |
| انقسام فتيلي شاذ | 1 |
| السيتوبلازم اليوزيني في> 75٪ من الخلايا السرطانية | 1 |
| معمارية منتشرة تزيد عن 33٪ من الورم | 1 |
| نخر | 1 |
| غزو وريدي | 1 |
| الغزو الجيبي (لا توجد عضلات ملساء في الجدار) | 1 |
| غزو المحفظة | 1 |
تشير النتيجة الإجمالية إلى:[16]
- 0-2: ورم قشر الكظر الغدي
- 3: غير محدد
- 4-9: سرطان قشر الكظر
العلاج
العلاج العلاجي الوحيد هو الاستئصال الجراحي الكامل للورم، والذي يمكن إجراؤه حتى في حالة غزو الأوعية الدموية الكبيرة، مثل الوريد الكلوي أو الوريد الأجوف السفلي. معدل البقاء على قيد الحياة لمدة 5 سنوات بعد الجراحة الناجحة هو 50-60٪، ولكن لسوء الحظ، فإن العديد من المرضى ليسوا مرشحين للجراحة. العلاج الإشعاعي والاستئصال الراديوي يمكن استخدامهم للرعاية التلطيفية في المرضى الذين ليسوا مرشحين للجراحة.[2] لا تزال التقنيات الجراحية طفيفة التوغل مثيرة للجدل بسبب عدم وجود بيانات طويلة الأجل، مع اهتمام خاص بمعدلات التكرار والداء السرطاني المنتشر البريتوني.[citation needed]
تشتمل أنظمة العلاج الكيميائي عادةً على عقار ميتوتان، وهو مثبط لتخليق السترويد، وهو سام لخلايا قشرة الغدة الكظرية،[18] بالإضافة إلى الأدوية القياسية السامة للخلايا. أظهر التحليل بأثر رجعي فائدة البقاء على قيد الحياة لميتوتان بالإضافة إلى الجراحة عند مقارنتها بالجراحة وحدها.[19]
والأنظمة الأكثر شيوعا هما سيسبلاتين، دوكسوروبيسين، إيتوبوسيد (EDP) + ميتوتان، و بالستربتوزوتوسين + ميتوتان. أظهرت تجربة FIRM-ACT معدلات استجابة أعلى وبقاء أطول بدون تقدم مع EDP + ميتوتان مقارنة بالستربتوزوتوسين + ميتوتان.[20]
المآل
بشكل عام، يحمل سرطان القشرة الكظرية تنبؤًا سيئًا،[21] مع معدل بقاء إجمالي لمدة 5 سنوات يبلغ حوالي 50٪.[1] تبلغ نسبة البقاء على قيد الحياة لمدة خمس سنوات خالية من الأمراض للاستئصال الكامل للمرحلة الأولى إلى الثالثة من التهاب المفاصل الرثياني حوالي 30٪.[21] أهم عوامل المآل هي عمر المريض ومرحلة الورم. تشمل العوامل المآل السيئة النشاط الانقسامي، والغزو الوريدي، ووزن 50 جم أو أكثر، وقطر 6.5 سم أو أكثر، مؤشر وضع العلامات Ki-67 / MIB1 بنسبة 4٪ أو أكثر، و p53 موجب..[citation needed]
في الورم الخبيث، يختلف سرطان القشرة الكظرية عن معظم أورام قشرة الغدة الكظرية، وهي أورام حميدة ( أورام غدية ) وتسبب متلازمة كوشينگ في بعض الأحيان فقط..[citation needed]
المراجع
- ^ أ ب "Adrenal Gland Tumor: Statistics". Cancer.net. Retrieved 2020-07-01.
- ^ أ ب ت ث ج DeVita VT, Hellman S, Rosenberg SA, eds. (2005). Cancer: principles & practice of oncology. Philadelphia: Lippincott-Raven. ISBN 978-0-7817-4865-0.
- ^ أ ب ت Savarese, Diane MF; Lynnette K Nieman (2006-08-08). "Clinical presentation and evaluation of adrenocortical tumors". UpToDate Online v. 15.1. UpToDate. Archived from the original on 2007-09-29. Retrieved 2007-06-05.
- ^ Wang T, Rainey WE (March 2012). "Human adrenocortical carcinoma cell lines". Molecular and Cellular Endocrinology. 351 (1): 58–65. doi:10.1016/j.mce.2011.08.041. PMC 3288152. PMID 21924324.
- ^ Gazdar AF, Oie HK, Shackleton CH, Chen TR, Triche TJ, Myers CE, Chrousos GP, Brennan MF, Stein CA, La Rocca RV (September 1990). "Establishment and characterization of a human adrenocortical carcinoma cell line that expresses multiple pathways of steroid biosynthesis". Cancer Research. 50 (17): 5488–96. PMID 2386954.
- ^ أ ب Cote R, Suster S, Weiss L (2002). Weidner N (ed.). Modern Surgical Pathology (2 Volume Set). London: W B Saunders. ISBN 978-0-7216-7253-3.
- ^ Cheungpasitporn W, Horne JM, Howarth CB (August 2011). "Adrenocortical carcinoma presenting as varicocele and renal vein thrombosis: a case report". Journal of Medical Case Reports. 5: 337. doi:10.1186/1752-1947-5-337. PMC 3160386. PMID 21806824.
{{cite journal}}: CS1 maint: unflagged free DOI (link) - ^ Kasper DL, Braunwald E, Fauci AS, Hauser SL, Longo DL, Jameson JL. Harrison's Principles of Internal Medicine. New York: McGraw-Hill, 2005. ISBN 0-07-139140-1
- ^ Zheng S, Cherniack AD, Dewal N, Moffitt RA, Danilova L, Murray BA, et al. (May 2016). "Comprehensive Pan-Genomic Characterization of Adrenocortical Carcinoma". Cancer Cell. 29 (5): 723–736. doi:10.1016/j.ccell.2016.04.002. PMC 4864952. PMID 27165744.
- ^ أ ب Assié G, Letouzé E, Fassnacht M, Jouinot A, Luscap W, Barreau O, et al. (June 2014). "Integrated genomic characterization of adrenocortical carcinoma". Nature Genetics. 46 (6): 607–12. doi:10.1038/ng.2953. PMID 24747642. S2CID 13089427.
- ^ Kufe D (2000). Benedict RC, Holland JF (eds.). Cancer medicine (5th ed.). Hamilton, Ont: B.C. Decker. ISBN 978-1-55009-113-7. OCLC 156944448.
- ^ James Norman. "Diseases of the Adrenal Cortex: Adrenal Cancer". EndocrineWeb. Updated on: 04/14/16
- ^ أ ب Albano, Domenico; Agnello, Francesco; Midiri, Federico; Pecoraro, Giusy; Bruno, Alberto; Alongi, Pierpaolo; Toia, Patrizia; Di Buono, Giuseppe; Agrusa, Antonino; Sconfienza, Luca Maria; Pardo, Salvatore (December 2019). "Imaging features of adrenal masses". Insights into Imaging (in الإنجليزية). 10 (1): 1. doi:10.1186/s13244-019-0688-8. ISSN 1869-4101. PMC 6349247. PMID 30684056.
{{cite journal}}: CS1 maint: unflagged free DOI (link) - ^ Data and references for pie chart are located at file description page in Wikimedia Commons.
- ^ Wang, Cuiping; Sun, Yang; Wu, Huanwen; Zhao, Dachun; Chen, Jie (2014). "Distinguishing adrenal cortical carcinomas and adenomas: a study of clinicopathological features and biomarkers". Histopathology. 64 (4): 567–576. doi:10.1111/his.12283. ISSN 0309-0167. PMC 4282325. PMID 24102952.
- ^ أ ب ت Aye, Than Than; Myint, Phone; Myint, Kyar Nyo Soe (2015). "Adrenocortical Oncocytoma Presenting with Gynaecomastia". Journal of the ASEAN Federation of Endocrine Societies. 30 (1): 27–30. doi:10.15605/jafes.030.01.08. ISSN 0857-1074.
- ^ Tito Fojo. "Adrenocortical Cancer". Retrieved 2020-07-02.
- ^ Brunton LL, Lazo JS, Parker KL, eds. (2006). Goodman & Gilman's The Pharmacological Basis of Therapeutics, 11th Edition. United States of America: The McGraw-Hill Companies, Inc. ISBN 978-0-07-142280-2.
- ^ Terzolo M, Angeli A, Fassnacht M, Daffara F, Tauchmanova L, Conton PA, et al. (June 2007). "Adjuvant mitotane treatment for adrenocortical carcinoma" (PDF). The New England Journal of Medicine. 356 (23): 2372–80. doi:10.1056/NEJMoa063360. hdl:2318/37317. PMID 17554118.
- ^ Fassnacht, Martin; Terzolo, Massimo; Allolio, Bruno; Baudin, Eric; Haak, Harm; Berruti, Alfredo; Welin, Staffan; Schade-Brittinger, Carmen; Lacroix, André (2012-06-07). "Combination chemotherapy in advanced adrenocortical carcinoma". The New England Journal of Medicine. 366 (23): 2189–2197. doi:10.1056/NEJMoa1200966. hdl:2318/102217. ISSN 1533-4406. PMID 22551107.
- ^ أ ب Allolio B, Fassnacht M (June 2006). "Clinical review: Adrenocortical carcinoma: clinical update". The Journal of Clinical Endocrinology and Metabolism. 91 (6): 2027–37. doi:10.1210/jc.2005-2639. PMID 16551738. Free Full Text.
وصلات خارجية
| Classification | |
|---|---|
| External resources |
- CS1 maint: unflagged free DOI
- الصفحات بخصائص غير محلولة
- Short description is different from Wikidata
- Articles with unsourced statements from August 2020
- Articles with unsourced statements from August 2013
- Articles with unsourced statements from April 2021
- Articles with unsourced statements from July 2011
- صفحات بها وصلات إنترويكي
- سرطانات نادرة
- أورام الغدد الصماء
- حالات جلدية متعلقة بالغدد الصماء
- اضطرابات الغدة الكظرية